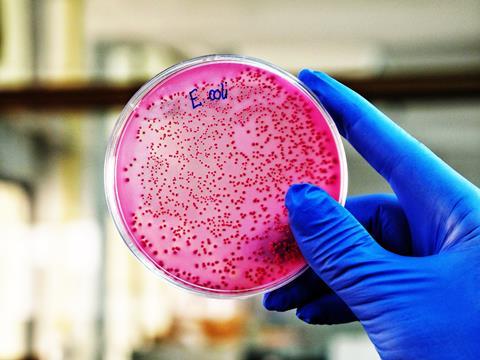
A,Scientist,Is,Holding,A,Plate,Of,E.,Coli,Growing

New study shows E. coli resists antibiotics by modifying its ribosome structure, blocking drug binding and enabling growth despite treatment.
A new study published in Nature Communications has uncovered a mechanism by which E. coli bacteria resist antibiotics. The research reveals that when exposed to drugs like streptomycin and kasugamycin, E. coli alters the structure of its ribosomes, the primary target of these antibiotics. Normally, these drugs work by binding to ribosomes and disrupting protein production. However, the bacteria modify their ribosomes in response, preventing effective binding and reducing the drugs' efficacy. This alteration enables the bacteria to continue growing, even in the presence of antibiotics.
The researchers found that, when exposed to antibiotics, E. coli began to produce ribosomes with slight structural changes. Depending on the antibiotic used, these new ribosomes lacked specific chemical tags, particularly in the regions where antibiotics normally bind to halt protein production. These alterations in ribosome structure made the bacteria more resistant to the drugs.
“We think the bacteria's ribosomes might be altering its structure just enough to prevent an antibiotic from binding effectively,” says Anna Delgado-Tejedor, first author of the study and PhD student at the Centre for Genomic Regulation (CRG) in Barcelona.
While bacteria are already known to develop resistance through mutations in their DNA or by actively pumping antibiotics out of their cells, this study highlights a previously unobserved survival strategy. E. coli appears to modify its ribosomes in real time, offering a subtle and stealthy way of evading antibiotics. “This is a stealthy way of dodging drugs,” says Dr Eva Novoa, corresponding author of the study and researcher at CRG.
The team used advanced nanopore sequencing technology to directly read RNA molecules, enabling them to observe the chemical modifications in their natural context. This allowed the researchers to detect the ribosome changes that other techniques might have missed.
While the study reveals how E. coli adapts to antibiotics, it does not yet explain why or how these modifications are lost when exposed to the drugs. Further research is needed to explore the biological mechanisms behind this adaptive process. Understanding how bacteria shed these modifications could lead to new strategies to combat antibiotic resistance, which is a growing global health threat. Antibiotic resistance currently claims at least one million lives annually and is projected to cause 39 million more deaths by 2050.
This study opens new avenues in the fight against antibiotic-resistant bacteria and offers hope for the development of innovative treatments to address one of the most pressing health challenges of our time.
This study was published in Nature Communications.







